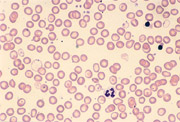

TALASSEMIA (o ANEMIA MEDITERRANEA
o MICROCITEMIA)
|

La talassemia (o anemia mediterranea o microcitemia) č una malattia ereditaria caratterizzata da un difetto nella sintesi dell'emoglobina, la proteina contenuta nei globuli rossi del sangue, che ha il compito di trasportare l'ossigeno alle diverse cellule del corpo e di eliminare l'anidride carbonica.
La molecola dell'emoglobina č formata da una testa, denominata eme, e da catene proteiche (globine), indicate con le lettere greche alfa, beta e gamma.
I difetti di una o piů di queste catene causano le diverse sindromi talassemiche, in particolare le alfa-talassemie e le beta-talassemie.
La forma piů diffusa in Italia e nell'area mediterranea č la beta-talassemia o anemia mediterranea, provocata da un'alterazione della catena globinica di tipo beta. Queste catene proteiche sono regolate da due geni che si trovano in due cromosomi omologhi, uno di origine paterna e uno di origine materna. Si possono avere due casi principali:
 1) L'individuo possiede un solo gene difettoso (forma eterozigote). In tal caso si parla di portatore sano e la disfunzione viene chiamata beta-talassemia minor.
1) L'individuo possiede un solo gene difettoso (forma eterozigote). In tal caso si parla di portatore sano e la disfunzione viene chiamata beta-talassemia minor.
La maggior parte dei soggetti con talassemia minor non presenta alcun sintomo di rilievo, tanto che molte persone ignorano di essere affetti da tale disfunzione.
In questi soggetti, i globuli rossi sono in numero maggiore che nei soggetti normali, ma sono un po' piů piccoli (di qui il termine di microcitemia) e piů poveri di emoglobina (intorno al 15% in meno rispetto alla norma). Circa il 20% dei soggetti presenta un leggero ingrossamento della milza.
Tuttavia, nella maggioranza dei casi, il gene ereditato dal genitore sano consente una produzione di globuli rossi e di emoglobina piů che sufficiente per condurre una vita normale.
2) Se un individuo possiede entrambi i geni difettosi (forma omozigote), ci troviamo di fronte a quella che viene chiamata beta-talassemia major o morbo di Cooley. Questa forma si manifesta nei bambini subito dopo la nascita con un notevole pallore della pelle, sintomo che rivela la presenza di una gravissima anemia:
i globuli rossi sono in numero ridotto, con una scarsa quantitŕ di emoglobina. Non sono perfettamente rotondi ma deformati in vario modo, molti sono soltanto dei frammenti.
Il paziente č costretto a periodiche trasfusioni di sangue (ogni 15-20 giorni) per tutta la vita. Le trasfusioni, perň, comportano inevitabilmente un eccessivo apporto di ferro, il quale finisce per accumularsi in organi importanti come il cuore, le ghiandole endocrine e il fegato, compromettendone le funzioni.
L'unico modo per evitare questo dannoso accumulo di ferro č quello di effettuare una corretta terapia con appositi farmaci (ferrochelanti).
Origini
La malattia, scoperta e descritta in una persona sana nel 1943 da due studiosi italiani, Ezio Silvestroni e Ida Bianco, ha probabilmente origine da mutazioni genetiche favorite da fattori ambientali.
I primi casi di cui si ha notizia riguardano i Fenici che, probabilmente, sono stati il veicolo di diffusione della malattia nell'area del Mediterraneo.
Diffusione
In Italia si contano circa 2 milioni e mezzo di portatori sani, concentrati soprattutto in Sardegna e in Sicilia, nelle regioni meridionali, ma anche nel delta padano e veneto.
All'estero, la malattia č frequente nell'Africa centrale, nel Sud-est asiatico, in Medio Oriente e in alcune zone dell'India.
In Italia vivono oggi circa 7.000 persone affette dalla forma omozigote di talassemia.
Trasmissione ereditaria
Possono verificarsi due casi:
1) uno soltanto dei genitori č microcitemico, mentre l'altro č normale. In tal caso, circa la metŕ dei figli eredita un gene normale e uno microcitemico (essi saranno perciň dei "portatori sani" della malattia); l'altra metŕ eredita due geni normali e i figli saranno del tutto normali.
Non ci sono possibilitŕ di generare figli ammalati della forma grave di talassemia.
2) Tutti e due i genitori sono microcitemici. Negli eventuali figli che nasceranno si avranno le seguenti probabilitŕ (teoriche):
a) 25% - individui sani
b) 50% - individui affetti da beta-talassemia minor (forma eterozigote di microcitemia)
c) 25% - individui ammalati gravi, con beta-talassemia major (forma omozigote).
Prevenzione
La probabilitŕ di generare figli affetti da talassemia major, se entrambi i genitori sono portatori sani di microcitemia, č del 25% (un bambino su 4 risulterŕ gravemente ammalato).
E' quindi molto importante, prima di mettere al mondo dei figli, che i genitori si sottopongano ad analisi specifiche tese a individuare la presenza di questa mutazione.
Se i portatori di microcitemia evitano di avere figli con altri portatori sani e scelgono un coniuge non microcitemico, non potranno avere figli con beta-talassemia major (la forma grave).
|
Rosario Mocciaro - Eugenio Lo Gullo, Thalassemia. Intervento psicologico-preventivo nell'anemia mediterranea, Kappa, Roma, 2003
Ida Bianca Silvestroni, Storia della microcitemia in Italia. Pagine di scienza e di vita, Giovanni Fioriti, Roma, 2002
Aurelio Maggio - Francesco Caronia - Giuseppe Russo, Clinica e terapia della talassemia, SEE, 2000
Franco Pepe, Fertilitŕ e beta-talassemia, Cofese, Palermo, 1994
Renato Cimino, La talassemia dell'Italia meridionale, Ospedale Cardarelli, Napoli, 1992
Bruno Marsala, Basi biochimiche e molecolari della talassemia, Piccin, Padova, 1987
Antonio Baserga, Aspetti internistici della talassemia minor, Pozzi Edizioni, 1981
Mario Corbo, Metodiche per il prelievo di sangue fetale nella diagnosi prenatale delle sindromi thalassemiche, Ricolo, Benevento, 1981
|

1) L'individuo possiede un solo gene difettoso (forma eterozigote). In tal caso si parla di portatore sano e la disfunzione viene chiamata beta-talassemia minor.
1) L'individuo possiede un solo gene difettoso (forma eterozigote). In tal caso si parla di portatore sano e la disfunzione viene chiamata beta-talassemia minor.